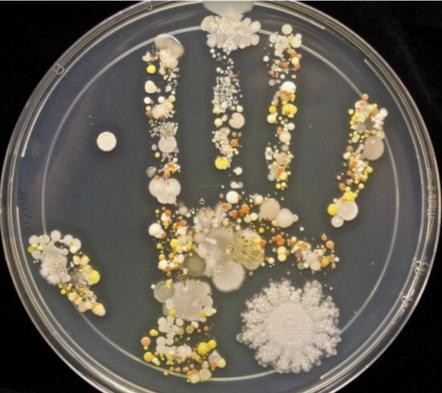
小孩身上起湿疹能用艾叶水洗么,孩子脸上起湿疹可以沾水吗

想必新手妈妈们对于宝宝出现的各种各样的状况都是一头雾水吧,不知道该怎么去应对。比如宝宝最容易起的湿疹,看着红彤彤的小疙瘩肯定觉得非常痛,那到底能不能沾水呢?今天我来给大家讲一下哦!


前几天,浙医婴幼儿门诊的医生遇到了一位有味道的宝宝
孩子刚进诊室,医生就闻到了一阵难闻的异味,仔细一看,只见:
3岁的男孩,头发已经粘成一束束的,身上除了红红的皮疹和一道道抓痕之外,还布满了一层层的污垢
一问才知道,孩子从过年到现在都没洗过澡
掐指一算,这足足有两个多月了!

这可真不怨父母偷懒,而是过年时这位小朋友的湿疹发作了
爸妈带他看诊时,医生说洗澡过多会加重病情,而冬天家里又冷,出于保护孩子,这才2个多月没给娃洗澡
因此,即便是他玩得一身汗,妈妈也只用湿毛巾擦拭,唯恐沾水加重了湿疹
想想3岁小男孩那活动量,两个月不洗澡
难怪医生未见其人,就先闻其味了
这也不难理解,父母为了孩子的健康,不得已才忍着异味遵医嘱
但患了湿疹,孩子真的不能洗澡吗?
当然不是


因为过度清洁会破坏皮肤的屏障作用,所以很多时候医生会特别叮嘱患儿家长少给孩子洗澡
但少洗 不洗啊~
而且,宝宝得了湿疹,不洗澡不但没有好处,还会造成诸多不良后果:
1)导致细菌病毒过度繁殖
美国微生物学家塔莎做过一个有趣的尝试:
在她8岁的儿子从外面玩耍归来之后,她让他印了一个手印接着,她将这个手印放在琼脂中培育了48小时
48小时后,琼脂是这个样子的:
图中的斑斑点点都是细菌的菌落!
其实不单是手上,我们的身体上也有大约1000多种不同类型的细菌80种真菌
在这些细菌中,有部分是有害的
如果不洗澡,这些有害的细菌病毒过敏原就会一直停留在皮肤上
并且,还会在在体表堆积的皮屑油污的滋养下,继续增长,致使已经发炎的皮肤再次发炎,加剧湿疹
2)丧失补水机会
儿科医生西尔斯博士曾指出:对湿疹患儿来说,干燥的皮肤是他们的敌人,而水分是他们最好的朋友
一般患有湿疹的宝宝皮肤就属于干燥敏感型再加上他们皮肤分泌的皮脂较少,特别容易失水,若不及时补水,则会使皮肤更加干燥
而除了喝水之外,温水浴也是很好的补水的途径
那不洗澡,就丧失了这么好的补水机会啦

3)导致宝宝情绪不佳
最近天气渐暖,正是湿疹的高发季节我儿子也不幸中招,他原本水嫩光滑的肌肤上密布着小红疹
湿疹造成的瘙痒和疼痛,让他整日哭闹,就连在睡梦中,小手都还在不安地挠着患处看了真是揪心不已
只有在洗澡的时候,宝宝才有片刻安宁
想想也是,湿疹本就造成了痛苦
若此时还不洗澡,粘附在皮肤上的污垢带来的黏腻感细菌代谢产生的酸臭味带来的不适,会更影响宝宝情绪吧


而且,给宝宝洗澡,既能湿润肌肤改善皮肤的屏障功能,缓解干燥带来的瘙痒;又能让血管舒张,让宝宝在精神上感到轻松舒服
美国儿科学会也建议,每天让湿疹患儿在温水中泡澡
但应注意如下几点:
1)水温
洗澡水温度不宜太高,2837为佳(手感温热即可)
即便是冬季也要在环境温暖孩子不着凉的前提下,尽量调低水温因为温度过高的话容易把皮肤本身表面的油脂成分过度清洗掉
2)时长
为防止宝宝皮肤上皮细胞因吸水过多而破裂,洗澡的时间不宜过长,510分钟就足够了
且为了更好地补水,沐浴方式推荐盆浴
3)避免刺激
沐浴过程中,尽量使用清水洗涤
若确实需要,也不要使用普通香皂沐浴液,可选用弱酸性无刺激沐浴露
因为,无论是婴儿液体皂还是条状香皂,其中的皂基都会让皮肤干燥,应选用添加保湿剂不带香味的天然产品
还有,宝宝的肌肤柔嫩,给他们洗澡动作要轻柔,切忌搓澡,以免损伤宝宝皮肤
包括给宝宝擦身的毛巾,都要选用柔软质地的无刺激材质
4)遵循先浸透,再锁水原则
刚洗完澡,皮肤角质层的水分还未散失
因此,给宝宝洗完澡后,要趁着宝宝皮肤湿润时,擦上温和无刺激的润肤霜,锁住水分,保持肌肤润泽


除此之外,护理一个患有湿疹的宝宝,要注意的还有很多
比如:
1)避免过敏原
医学研究表明,将近30%-40%的孩子在患湿疹的同时又有食物过敏,因此在日常生活中,家长需要注意避免过敏原
在饮食上,提倡母乳喂养
待宝宝添加辅食时,要注意每添加一种食物后,如1-2周未有皮肤过敏等发作,才继续尝试下一种食物
借此探明可疑的过敏食物,对于不过敏的食物可以继续食用,而过敏的食物则应回避

在日常用具上,也要十分小心
比如,衣物要选取全棉材质,避免羊毛绒毛化纤珊瑚绒等材质;房间通风清洁凉爽,勤换洗衣服和床单,不铺地毯,家里尽量不养宠物,不种植花草,减少对皮肤的刺激
2)保持宝宝体感温度适宜
很多家长怕孩子着凉感冒,哪怕天热了,也会给宝宝多穿一点
有时害了孩子的,恰恰是这点爱护
要知道,过热出汗是诱发和加重湿疹最主要的刺激因素因此,要避免给孩子穿盖太多,保持体感温度适宜,才能帮孩子缓解不适
当然,孩子患了湿疹,妈妈不要过分焦虑和自责,很多宝宝的湿疹会随着年龄的增加而逐渐消失
要知道,我们心态平和,才能更好的照顾孩子
好啦,今天的分享就到这里啦。
妈妈们还有哪些宝宝的状况不知道怎么解决的可以在下方留言哦
梁一感谢大家的阅读!
(以上图片均来自网络,如有侵权,请联系小编删除,谢谢合作)